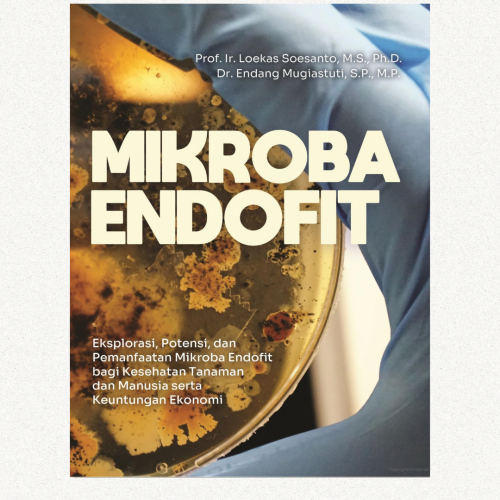
konten-buku-mikroba-endofit Mikroba Endofit

Buku ini membahas semua jenis penyakit tanaman kelapa karena fitoplasma, gangguan fisiologis, dan kahat hara. Setiap penyakit tanaman dibahas lengkap penyebabnya, klasifikasi, gejala penyakit kisaran tanaman inang, faktor yang sesuai, dan beragam upaya pengelolaan penyakit.
PROFIL
L
oekas Soesanto, lahir di Pati pada 26 Juni 1960 adalah seorang ahli di bidang Ilmu Penyakit Tanaman yang memperoleh gelar Ph.D dari University of Wageningen Belanda pada tahun 2000 dengan disertasi berjudul “Ecology and Biological Control of Verticillium dahliae”.Dianugerahkan jabatan menjadi guru besar di tahun 2008 dan saat ini menjabat sebagai Dosen Tetap di Fakultas Pertanian Universitas Jenderal Soedirman (Unsoed), Purwokerto serta ketua PFI Komisariat Daerah wilayah Kedu, Pekalongan, dan Banyumas.
Aktif sebagai pembicara di seminar nasional dan internasional, dosen tamu di berbagai universitas dan telah menerbitkan buku dan kompendium tentang penyakit tanaman, pestisida hayati, dan teknologi tepat guna.